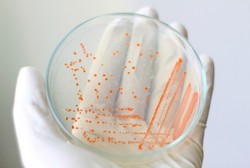
Lutut Luka Akibat Jatuh, Murid SMP Ini Terinfeksi Bakteri Pemakan Daging

Sepakbola
Diagnosis, Kunci Keberhasilan Penyembuhan Cedera
Prinsip dasar dari sebuah penanganan cedera adalah: kita tahu apa yang kita rawat. Maka dari itu, kunci keberhasilan penyembuhan cedera adalah diagnosis yang benar dan tepat. Terdengarnya mudah, tapi prakteknya tak sembarangan.
Selasa, 29 Okt 2013 13:08 WIB